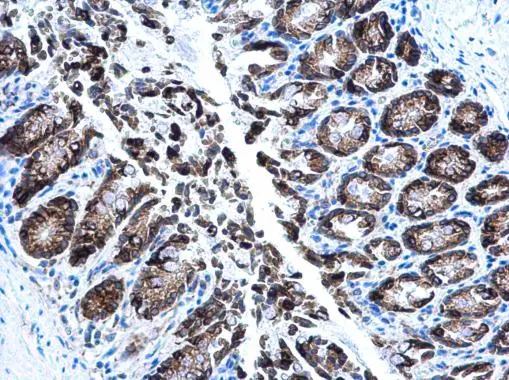
AGR2 antibody detects AGR2 protein at cytoplasm in mouse colon by immunohistochemical analysis. Sample: Paraffin-embedded mouse colon. AGR2 antibody (GTX130229) diluted at 1:500. 
 Antigen Retrieval: Citrate buffer, pH 6.0, 15 min

AGR2 antibody detects AGR2 protein at cytoplasm by immunofluorescent analysis. Sample: MCF7 cells were fixed in 4% paraformaldehyde at RT for 15 min. Green: AGR2 protein stained by AGR2 antibody (GTX130229) diluted at 1:1000. Blue: Hoechst 33342 staining. Scale bar = 10 μm.
Anterior Gradient 2 antibody
GTX130229
ApplicationsImmunoFluorescence, ImmunoPrecipitation, Western Blot, ImmunoCytoChemistry, ImmunoHistoChemistry, ImmunoHistoChemistry Paraffin
Product group Antibodies
ReactivityHuman, Mouse
TargetAGR2
Overview
- SupplierGeneTex
- Product NameAnterior Gradient 2 antibody
- Delivery Days Customer9
- Application Supplier NoteWB: 1:500-1:3000. ICC/IF: 1:100-1:1000. IHC-P: 1:100-1:1000. IP: 1:100-1:500. *Optimal dilutions/concentrations should be determined by the researcher.Not tested in other applications.
- ApplicationsImmunoFluorescence, ImmunoPrecipitation, Western Blot, ImmunoCytoChemistry, ImmunoHistoChemistry, ImmunoHistoChemistry Paraffin
- CertificationResearch Use Only
- ClonalityPolyclonal
- Concentration0.2 mg/ml
- ConjugateUnconjugated
- Gene ID10551
- Target nameAGR2
- Target descriptionanterior gradient 2, protein disulphide isomerase family member
- Target synonymsAG-2, AG2, GOB-4, HAG-2, HEL-S-116, HPC8, PDIA17, RIFTD, XAG-2, anterior gradient protein 2 homolog, anterior gradient homolog 2, epididymis secretory protein Li 116, protein disulfide isomerase family A, member 17, secreted cement gland homolog, secreted cement gland protein XAG-2 homolog
- HostRabbit
- IsotypeIgG
- Protein IDO95994
- Protein NameAnterior gradient protein 2 homolog
- ReactivityHuman, Mouse
- Storage Instruction-20°C or -80°C,2°C to 8°C
- UNSPSC41116161